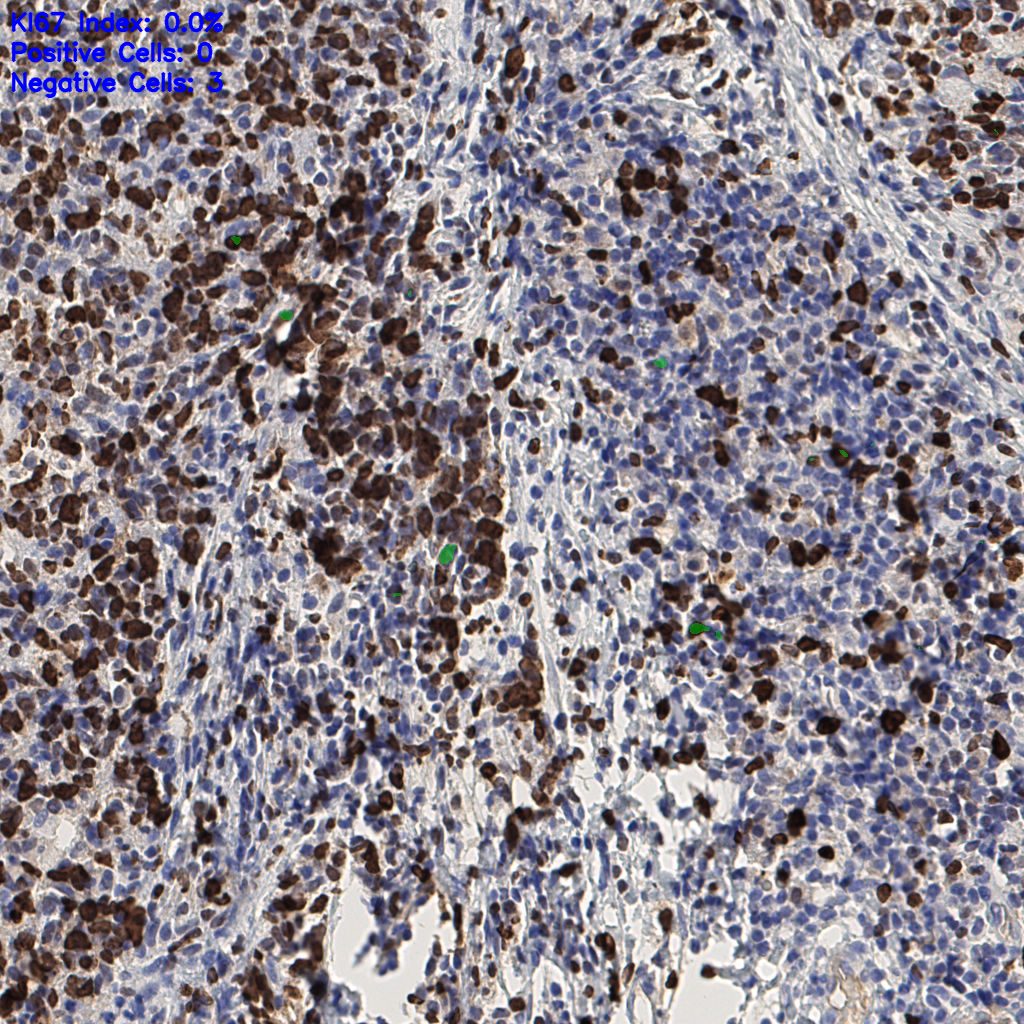
slice_43_6_x38528_y5376.png

7.85%
Ki67 指数
阴 1104
阳 94
处理信息
状态
处理完成
上传
2026-04-10 10:30
耗时
2617秒
切片统计
总切片
1953
有效
288
已标记
288
有效率
15%

slice_42_4_x37632...

slice_42_5_x37632...

slice_42_6_x37632...

slice_42_7_x37632...

slice_43_2_x38528...

slice_43_3_x38528...

slice_43_4_x38528...

slice_43_5_x38528...
slice_43_6_x38528...

slice_43_7_x38528...

slice_43_8_x38528...

slice_43_9_x38528...

slice_44_10_x3942...

slice_44_12_x3942...

slice_44_13_x3942...

slice_44_15_x3942...

slice_44_17_x3942...

slice_44_18_x3942...

slice_44_2_x39424...

slice_44_3_x39424...
